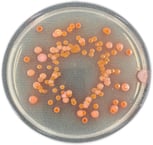
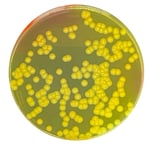
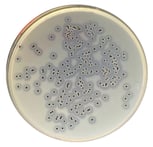

CSC微生物検査関連製品 オンライン展示

CSC培地シリーズ
標準寒天培地
コロニーが赤く生育!
カウント効率が飛躍的に⤴
コロニーが赤く生育することで残渣との判別が容易となり、カウント効率が飛躍的に上がります。
お手持ちのスパイラルプレーター、コロニーカウンターでのご使用も有用です。
黄色ブドウ球菌用生培地
卵黄加マンニット食塩寒天培地
食品・臨床材料等からStaphylococcus aureusを分離します。生菌数の測定に使用可能です。
従来品と比べ、特殊精製した卵黄液を使用することにより、卵黄反応が明瞭で24時間が培養で選択分離することが可能です。
製品動画
ベアードパーカー寒天培地
ピルビン酸ナトリウムにより食品加工工程等で損傷した菌の発育を促進します。S.epidermidis を含む多くのコアグラーゼ陰性は、抑制されるか卵黄反応のない小さな黒色集落を形成するので判別が容易です。
食肉製品の規格基準、ISO、JISおよび日本薬局方で定められた培地です。


微生物検査の省力化・自動化は
信頼と実績のセントラル科学貿易にお任せください!!
こちらの動画にて省力化機器をご紹介しております。

セントラル科学貿易では、
この他にも様々な製品を取り扱っております。
最新版の製品ピックアップガイドはこちらから
ダウンロード頂けます!!
コロナ禍における感染防止関連製品も多数ラインナップ!
セントラル科学貿易では、このほかにも感染予防対策のお役に立つ製品を多数
取り揃えております。

~セントラル科学貿易にて、デモ実施・製品をご購入頂くメリット~
販売からアフターサービスまで!
- 理化学機器輸入商社として、創業から50年以上の豊富な経験と実績
- 海外メーカーとの協力体制による、信頼のアプリケーションサポート
- 保守点検から修理対応まで、万全の技術サービス体制
資料請求/お問合せ
フォームが表示されるまでしばらくお待ち下さい。
恐れ入りますが、しばらくお待ちいただいてもフォームが表示されない場合は、こちらまでお問い合わせください。





